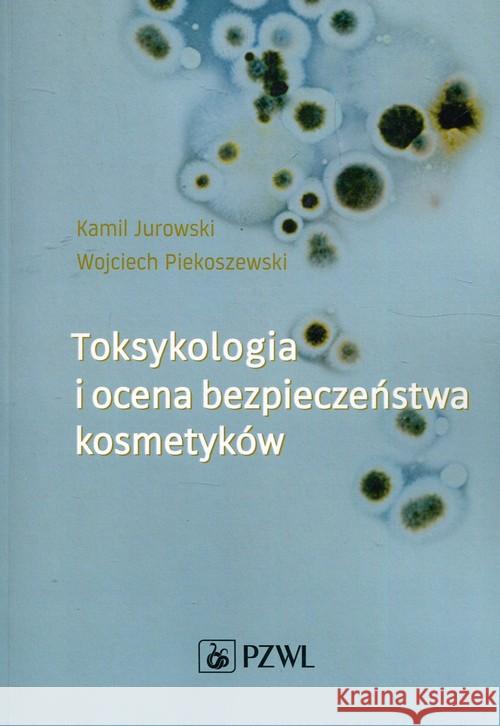
Toksykologia i ocena bezpieczeństwa kosmetyków Jurowski Kamil Piekoszewski Wojciech 9788320056853

topmenu
Wyniki wyszukiwania:
wyszukanych pozycji: 3
 |
Toksykologia w zadaniach Część 2
ISBN: 9788320060102 / Polski / Miękka / 2020 / 210 str. Termin realizacji zamówienia: ok. 6-8 dni roboczych. Dwuczęściowa Toksykologia w zadaniach to nowoczesna publikacja, która została napisana z myślą o studentach medycyny, farmacji, diagnostyki medycznej, kierunków przyrodniczych.
Stanowi ona także doskonałe źródło pomocy dla wykładowców podczas przygotowywania zajęć oraz zaliczeń. Ponadto jest kompatybilna z dwutomowym podręcznikiem Toksykologia oraz stanowi jego uzupełnienie. Zaprezentowane w publikacji rozdziały zostały zawierają pełne rozwiązania zadań oraz ważne komentarze, wyjaśniające poruszaną kwestię. Redaktorami naukowymi książki są dr Kamil Jurowski... Dwuczęściowa Toksykologia w zadaniach to nowoczesna publikacja, która została napisana z myślą o studentach medycyny, farmacji, diagnostyki medy...
|
cena:
84,00 |
 |
Toksykologia w zadaniach Część 1
ISBN: 9788320060096 / Polski / Miękka / 2020 / 245 str. Termin realizacji zamówienia: ok. 6-8 dni roboczych. Dwuczęściowa Toksykologia w zadaniach to nowoczesna publikacja przeznaczona nie tylko dla studentów medycyny, farmacji, diagnostyki medycznej, kierunków przyrodniczych, ale również pozycja dla nauczycieli akademickich, którym zadania mogą pomóc w przygotowaniu zaliczeń oraz prowadzeniu zajęć.
Książka została przygotowana przez dr Kamila Jurowskiego (toksykologa, safety assessor) oraz prof. dr hab. Wojciecha Piekoszewskiego (specjalistę z zakresu toksykologii: sądowej, klinicznej, ekotoksykologii i żywności). Nauka toksykologii, która polega na rozwiązywaniu zadań... Dwuczęściowa Toksykologia w zadaniach to nowoczesna publikacja przeznaczona nie tylko dla studentów medycyny, farmacji, diagnostyki medycznej, kier...
|
cena:
84,00 |
|
Toksykologia i ocena bezpieczeństwa kosmetyków
ISBN: 9788320056853 / Polski / Miękka / 2019 / 450 str. Termin realizacji zamówienia: ok. 6-8 dni roboczych. Książka, jakiej jeszcze nie było na polskim rynku wydawniczym! Autorzy w sposób kompleksowy przedstawiają aspekty zarówno teoretyczne, jak i praktyczne w zakresie toksykologii i oceny bezpieczeństwa kosmetyków. Całość podzielono na trzy części: podstawy toksykologii ogólnej, toksykologię kosmetyków i ocenę bezpieczeństwa. Niezbędnik dla studentów kosmetologii, chemii kosmetycznej, chemii, biochemii, biotechnologii oraz dermatologów, alergologów, poczatkujących safety assessorów i praktyków.
Publikacja ta będzie doskonałym źródłem wiedzy dla studentów, cenną... Książka, jakiej jeszcze nie było na polskim rynku wydawniczym! Autorzy w sposób kompleksowy przedstawiają aspekty zarówno teoretyczne, jak i pra...
|
cena:
163,99 |










